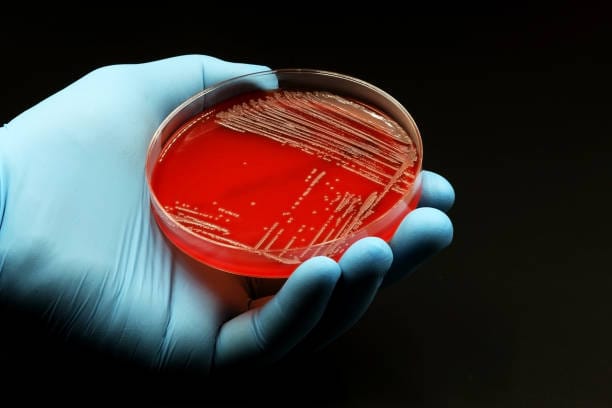

A groundbreaking discovery has been made by an international team of geologists, paleontologists, and climate scientists from Mexico, the U.S., and Spain. In their recent study published in the journal Cretaceous Research, they have identified a new genus and species of dinosaur within the Ornithomimidae family. This exciting discovery sheds light on a previously unknown dinosaur that lived around 73 million years ago and adds a new chapter to our understanding of the diverse and fascinating world of theropods.
Ornithomimidae Family: Ostrich-like Dinosaurs
The Ornithomimidae family, often referred to as the “ostrich dinosaurs,” includes theropods that closely resemble the modern ostrich. These dinosaurs were primarily characterized by their bipedal, fast-running bodies, which made them highly efficient in terms of mobility. Early research on the family indicated that they were herbivorous or omnivorous, and they primarily roamed Laurasia (the northern supercontinent) during the Late Cretaceous Period. While this family is most commonly associated with North America and Asia, there have also been reports of similar species from Australia’s Lower Cretaceous Wonthaggi Formation.
Ornithomimids generally shared several physical traits, including long necks, forelimbs, and hindlimbs, as well as small heads relative to their bodies. These characteristics helped define their ecological role as fast-moving, adaptable creatures that likely foraged for food and avoided larger predators through their speed.
The Discovery in Coahuila, Mexico
The discovery of the new dinosaur, Mexidracon longimanus, dates back to 2014 when a team of archaeologists and paleontologists unearthed fossilized remains at a dig site in Coahuila, a state in northern Mexico. At first, the remains were unidentifiable, and the fossils were sent to Benemérita Escuela Normal de Coahuila for further examination. It wasn’t until recent years that a more comprehensive study was initiated, leading to the identification of the remains as belonging to an entirely new species.
This discovery adds another layer of significance to the region’s rich paleontological record, which has already yielded many important fossils from the Mesozoic era. The research team’s detailed examination showed that the remains were from an ancient dinosaur that had not been seen before, and they named it Mexidracon longimanus after the area of discovery and its notable anatomical features.
A Unique Fossil and Its Importance
Upon conducting a phylogenetic analysis of the fossilized remains, the research team confirmed that Mexidracon longimanus was indeed a member of the Ornithomimidae family. However, the dinosaur also had distinct features that set it apart from its relatives. The most notable of these features was its extremely long metacarpals, which are the bones in the hand that connect to the fingers.
These long metacarpals resulted in unusually long hands, with palms that were longer than the dinosaur’s upper arm. This unique characteristic immediately captured the attention of the researchers, as it suggested an ecological adaptation that was unlike other members of the family. The team hypothesized that these long hands may have been used to reach into shrubs or trees to pull down branches or twigs. This would have been an effective feeding strategy for a dinosaur that lived in a rich, forest-like environment.
Comparisons to Modern Animals
The researchers drew comparisons between the hands of Mexidracon longimanus and those of modern tree sloths. Like sloths, which use their long, curved claws to reach high up in trees and pull down vegetation, Mexidracon longimanus may have employed its elongated hands to reach higher vegetation or smaller shrubs near the ground. This feeding behavior could explain the dinosaur’s long arms and hands, allowing it to gather plant material or small animals that may have been living in those environments.
Moreover, the team speculated that the dinosaur’s long hands could have been advantageous for catching small prey, particularly creatures that lived near the water’s edge. This suggests that Mexidracon longimanus may have had a mixed diet that included both plant material and small animals, an omnivorous diet commonly seen in other members of the Ornithomimidae family.
The Importance of Phylogenetic Analysis
The phylogenetic analysis conducted by the research team was critical in establishing the evolutionary relationship of Mexidracon longimanus within the Ornithomimidae family. The team found that Mexidracon longimanus shared a polytomic relationship with other members of the clade, meaning it was related to several other species in a branching family tree. This analysis helps scientists understand how the Ornithomimidae family evolved over millions of years and how different species adapted to their environments.
The study of Mexidracon longimanus has provided researchers with valuable insights into the diversity of theropod dinosaurs. It suggests that the Ornithomimidae family was far more varied in its anatomical features and behaviors than previously thought. The long arms and hands of this dinosaur represent a new adaptation that challenges some of the assumptions made about the family and opens up new possibilities for future research.
Ecological Context and Habitat
Mexidracon longimanus likely lived in a diverse, vegetated landscape with abundant shrubs, trees, and water sources. This environment would have been ideal for a dinosaur that relied on both plant matter and small prey for sustenance. During the Late Cretaceous, the region of what is now Mexico was likely home to various theropod dinosaurs, herbivores, and small mammals.
The long arms of Mexidracon longimanus suggest that it could have played a significant role in its ecosystem, whether by foraging for plants, interacting with small prey, or even competing with other animals for food. Its omnivorous diet would have allowed it to be a versatile forager, feeding on whatever was available in its habitat.
Conclusion: A New Window into Dinosaur Evolution
The discovery of Mexidracon longimanus adds an exciting new dimension to our understanding of the Ornithomimidae family and the broader world of theropod dinosaurs. The dinosaur’s unique anatomical features, such as its long hands and arms, provide valuable insights into the diversification of species within the family. This new species also underscores the complexity and adaptability of dinosaurs during the Late Cretaceous Period, a time of great ecological diversity.
As scientists continue to study and analyze the fossil remains of Mexidracon longimanus, it is likely that even more discoveries will emerge, further deepening our understanding of dinosaur evolution and behavior. For now, this exciting find serves as a reminder of the incredible diversity of life that once roamed the Earth and the ongoing importance of paleontological research in uncovering the mysteries of our planet’s distant past.
Reference: Claudia Inés Serrano-Brañas et al, A long-handed new ornithomimid dinosaur from the Campanian (Upper Cretaceous) Cerro del Pueblo Formation, Coahuila, Mexico, Cretaceous Research (2025). DOI: 10.1016/j.cretres.2025.106087